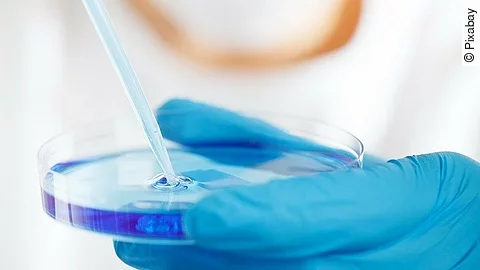
Forschung Forschung

Chinesisch-Deutsche Lösungsansätze
Die Mainzer Biotech-Firma Biontech will mit einem chinesischen Partner einen Impfstoff gegen den Covid-19-Erreger entwickeln. BioNTech und Fosun Pharma in Shanghai vereinbarten dazu gemeinsame klinische Studien. Der Kandidat für einen geplanten Impfstoff soll Körperzellen anregen, Wirkstoffe zur Abwehr des Virus zu erzeugen. Bei einer Zulassung soll Fosun Pharma den Impfstoff in China vermarkten, außerhalb der Volksrepublik hätte BioNTech dagegen die Vermarktungsrechte. An der Börse legten BioNTech-Aktien daraufhin stark zu. Die Firma gilt wegen ihrer breiten Entwicklungsplattform als gut aufgestellt im Rennen um einen Coronavirus-Impfstoff.
Bildgebung und Künstliche Intelligenz
Der Chef des Medizintechnik-Konzerns Siemens Healthineers, Bernd Montag, berichtet: „Teilweise sehen wir ein deutlich gesteigertes Interesse an unseren bildgebenden Geräten.“ Computertomografen kämen zum Einsatz, um Patienten mit akutem oder drohendem Lungenversagen zu überwachen und nötige Therapien sicherzustellen. Zudem arbeite Siemens Healthineers an der Entwicklung eines Coronavirus-Tests, der nicht an eine bestimmte Analyseplattform gebunden sei. Das Unternehmen will auch mithilfe Künstlicher Intelligenz (KI) Systeme entwickeln, um Veränderungen des Lungengewebes im Computertomographen schneller erkennen zu können. Außerdem soll medizinisches Personal künftig Diagnosen mit digitalen Diensten ortsunabhängig - und damit ohne Ansteckungsrisiko - stellen können.

Derzeit sind noch keine Kommentare vorhanden. Schreiben Sie den ersten Kommentar!
Jetzt einloggen